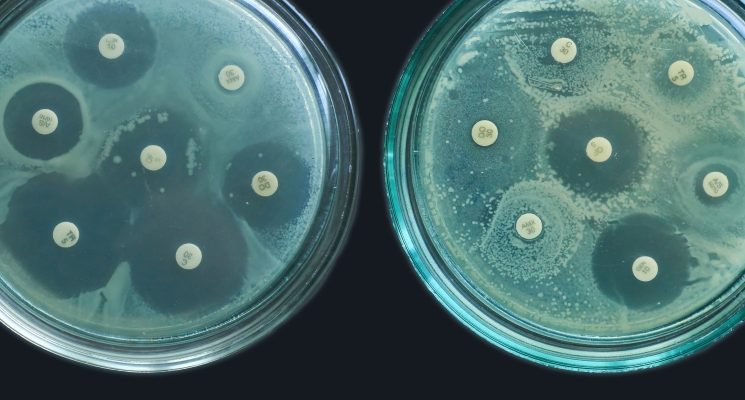

Агроэкономика и Рынки
Международный Контроль: Как Нам Уберечь Растения и Себя от Стимуляторов Роста Приветствуем вас, дорогие читатели! Сегодня мы погрузимся в важную и часто
Контроль за Импортными Стимуляторами Роста: Наш Опыт и Советы Приветствуем вас‚ дорогие читатели! Сегодня мы хотим поделиться нашим опытом‚
Стимуляторы Роста: Закон, Личный Опыт и Как Не Переступить Черту Приветствую, друзья! Сегодня мы поговорим о теме, которая затрагивает многих садоводов
Гормоны Роста: Как Мы Вернули Контроль и Изменили Жизнь Все мы стремимся к лучшему: быть здоровыми, энергичными, сильными. В погоне за этими идеалами
Гормональный баланс на ферме: Как мы защищаем ваш стол от нежелательных добавок Приветствую вас, дорогие читатели! Сегодня мы хотим поделиться с вами очень
Контроль за Использованием Гормонов в Животноводстве: Защита Потребителя и Благополучие Животных Приветствую вас, дорогие читатели! Сегодня мы поговорим
Контроль за использованием гормонов: Путь к здоровому телу и разуму В современном мире, где стремление к идеальному телу и высокой продуктивности порой
ГМО: Друг или Враг? Наш Личный Опыт и Размышления Генетически модифицированные организмы (ГМО) – тема, которая вызывает бурные споры и разногласия.
Антибиотики в животноводстве: Как мы теряем лекарство, которое может спасти нас всех Мы часто слышим о проблеме устойчивости к антибиотикам, но редко задумываемся
Контроль за Использованием Антибиотиков: Наш Опыт и Рекомендации В современном мире, где антибиотики стали неотъемлемой частью лечения бактериальных инфекций